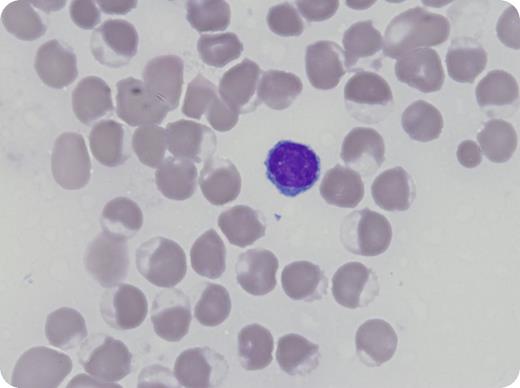
A 50-year-old African American man with no known medical history presented with shortness of breath and leukocytosis. Biopsy specimens of an anterior mediastinal mass showed T-lymphoblastic leukemia/lymphoma. Rasburicase was administered for tumor lysis syndrome, leading to hypoxia, hyperkalemia, and methemoglobinemia within 24 hours. Review of a peripheral smear showed findings consistent with hemolysis, with erythrocyte changes including near-diffuse bite cells, helmet cells, blister cells, and frequent nucleated red blood cells (Wright Giemsa stain, original magnification ×1000). A methylene blue–stained peripheral blood smear showed Heinz bodies. Methylene blue was administered without significant improvement. Subsequent testing for glucose-6-phosphate dehydrogenase deficiency (G6PD) upon resolution confirmed enzyme deficiency. / Patients with G6PD deficiency are unable to convert glucose-6-phosphate into 6-phosphogluconolactone. The resultant accumulation of reactive oxygen species within erythrocytes leads to oxidation of hemoglobin (methemoglobin) and accumulation of denatured hemoglobin, which can result in hemolytic anemia, reduced arterial oxygen saturation on pulse oximetry, and impaired oxygen delivery to tissues from methemoglobin, often necessitating supplemental oxygen. Although G6PD testing is recommended prior to rasburicase administration, it is often not practical because of disease acuity. However, if feasible, testing for G6PD deficiency in patients of high-prevalence ethnicities should be considered before administration of this medication and methylene blue administration avoided.

A 50-year-old African American man with no known medical history presented with shortness of breath and leukocytosis. Biopsy specimens of an anterior mediastinal mass showed T-lymphoblastic leukemia/lymphoma. Rasburicase was administered for tumor lysis syndrome, leading to hypoxia, hyperkalemia, and methemoglobinemia within 24 hours. Review of a peripheral smear showed findings consistent with hemolysis, with erythrocyte changes including near-diffuse bite cells, helmet cells, blister cells, and frequent nucleated red blood cells (Wright Giemsa stain, original magnification ×1000). A methylene blue–stained peripheral blood smear showed Heinz bodies. Methylene blue was administered without significant improvement. Subsequent testing for glucose-6-phosphate dehydrogenase deficiency (G6PD) upon resolution confirmed enzyme deficiency.
Patients with G6PD deficiency are unable to convert glucose-6-phosphate into 6-phosphogluconolactone. The resultant accumulation of reactive oxygen species within erythrocytes leads to oxidation of hemoglobin (methemoglobin) and accumulation of denatured hemoglobin, which can result in hemolytic anemia, reduced arterial oxygen saturation on pulse oximetry, and impaired oxygen delivery to tissues from methemoglobin, often necessitating supplemental oxygen. Although G6PD testing is recommended prior to rasburicase administration, it is often not practical because of disease acuity. However, if feasible, testing for G6PD deficiency in patients of high-prevalence ethnicities should be considered before administration of this medication and methylene blue administration avoided.
A 50-year-old African American man with no known medical history presented with shortness of breath and leukocytosis. Biopsy specimens of an anterior mediastinal mass showed T-lymphoblastic leukemia/lymphoma. Rasburicase was administered for tumor lysis syndrome, leading to hypoxia, hyperkalemia, and methemoglobinemia within 24 hours. Review of a peripheral smear showed findings consistent with hemolysis, with erythrocyte changes including near-diffuse bite cells, helmet cells, blister cells, and frequent nucleated red blood cells (Wright Giemsa stain, original magnification ×1000). A methylene blue–stained peripheral blood smear showed Heinz bodies. Methylene blue was administered without significant improvement. Subsequent testing for glucose-6-phosphate dehydrogenase deficiency (G6PD) upon resolution confirmed enzyme deficiency.
Patients with G6PD deficiency are unable to convert glucose-6-phosphate into 6-phosphogluconolactone. The resultant accumulation of reactive oxygen species within erythrocytes leads to oxidation of hemoglobin (methemoglobin) and accumulation of denatured hemoglobin, which can result in hemolytic anemia, reduced arterial oxygen saturation on pulse oximetry, and impaired oxygen delivery to tissues from methemoglobin, often necessitating supplemental oxygen. Although G6PD testing is recommended prior to rasburicase administration, it is often not practical because of disease acuity. However, if feasible, testing for G6PD deficiency in patients of high-prevalence ethnicities should be considered before administration of this medication and methylene blue administration avoided.
For additional images, visit the ASH Image Bank, a reference and teaching tool that is continually updated with new atlas and case study images. For more information, visit http://imagebank.hematology.org.